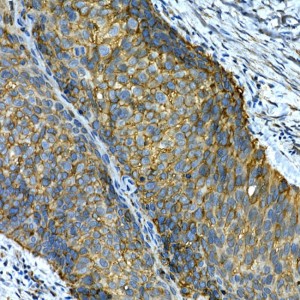
KO-Validated Integrin alpha 2 (ITGA2/CD49b) Rabbit pAb (20 μl)

KO-Validated Integrin alpha 2 (ITGA2/CD49b) Rabbit pAb (20 μl)
| Reactivity: | Human, Mouse, Rat |
| Applications: | WB, IHC, IF/IC, ELISA |
| Host Species: | Rabbit |
| Isotype: | IgG |
| Clonality: | Polyclonal antibody |
| Gene Name: | integrin subunit alpha 2 |
| Gene Symbol: | ITGA2 |
| Synonyms: | BR; GPIa; CD49B; HPA-5; VLA-2; VLAA2; b) |
| Gene ID: | 3673 |
| UniProt ID: | P17301 |
| Immunogen: | A synthetic peptide corresponding to a sequence within amino acids 30-162 of human Integrin alpha 2 (ITGA2/CD49b) (NP_002194.2). |
| Dilution: | WB 1:500-1:1000; IHC 1:50-1:200; IF/IC 1:50-1:200 |
| Purification Method: | Affinity purification |
| Concentration: | 0.48 mg/ml |
| Buffer: | PBS with 0.02% sodium azide, 50% glycerol ,pH7.3. |
| Storage: | Store at -20°C. Avoid freeze / thaw cycles. |
| Documents: | Manual-ITGA2 polyclonal antibody |
Background
This gene encodes the alpha subunit of a transmembrane receptor for collagens and related proteins. The encoded protein forms a heterodimer with a beta subunit and mediates the adhesion of platelets and other cell types to the extracellular matrix. Loss of the encoded protein is associated with bleeding disorder platelet-type 9. Antibodies against this protein are found in several immune disorders, including neonatal alloimmune thrombocytopenia. This gene is located adjacent to a related alpha subunit gene. Alternative splicing results in multiple transcript variants.
Images
 | Western blot analysis of various lysates using [KO Validated] Integrin alpha 2 (ITGA2/CD49b) Rabbit pAb (A7629) at 1:1000 dilution. Secondary antibody: HRP-conjugated Goat anti-Rabbit IgG (H+L) (AS014) at 1:10000 dilution. Lysates/proteins: 25μg per lane. Blocking buffer: 3% nonfat dry milk in TBST. Detection: ECL Basic Kit (RM00020). Exposure time: 90s. |
 | Western blot analysis of lysates from wild type (WT) and Integrin alpha 2 (ITGA2/CD49b) knockout (KO) 293T cells, using [KO Validated] Integrin alpha 2 (ITGA2/CD49b) Rabbit pAb (A7629) at 1:1000 dilution. Secondary antibody: HRP-conjugated Goat anti-Rabbit IgG (H+L) (AS014) at 1:10000 dilution. Lysates/proteins: 25μg per lane. Blocking buffer: 3% nonfat dry milk in TBST. Detection: ECL Basic Kit (RM00020). Exposure time: 90s. |
 | Immunohistochemistry analysis of paraffin-embedded Human lung cancer using [KO Validated] Integrin alpha 2 (ITGA2/CD49b) Rabbit pAb (A7629) at dilution of 1:50 (40x lens). High pressure antigen retrieval performed with 0.01M Citrate Bufferr (pH 6.0) prior to IHC staining. |
 | Immunohistochemistry analysis of paraffin-embedded Human placenta using [KO Validated] Integrin alpha 2 (ITGA2/CD49b) Rabbit pAb (A7629) at dilution of 1:50 (40x lens). High pressure antigen retrieval performed with 0.01M Citrate Bufferr (pH 6.0) prior to IHC staining. |
 | Immunohistochemistry analysis of paraffin-embedded Human tonsil using [KO Validated] Integrin alpha 2 (ITGA2/CD49b) Rabbit pAb (A7629) at dilution of 1:50 (40x lens). High pressure antigen retrieval performed with 0.01M Citrate Bufferr (pH 6.0) prior to IHC staining. |
 | Immunofluorescence analysis of U2OS cells using [KO Validated] Integrin alpha 2 (ITGA2/CD49b) Rabbit pAb (A7629) at dilution of 1:100. Secondary antibody: Cy3-conjugated Goat anti-Rabbit IgG (H+L) (AS007) at 1:500 dilution. Blue: DAPI for nuclear staining. |
You may also be interested in: